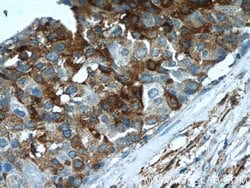
Paxillin Rabbit anti-Canine, Human, Mouse, Polyclonal, Proteintech 20 &mu;L;
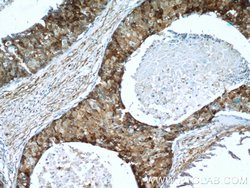
Paxillin Rabbit anti-Canine, Human, Mouse, Polyclonal, Proteintech 20 &mu;L;

missing translation for 'onlineSavingsMsg'
Learn More
Learn More
Paxillin Rabbit anti-Canine, Human, Mouse, Polyclonal, Proteintech
Rabbit Polyclonal Antibody
Brand: Proteintech 22172-1-AP-20UL
This item is not returnable.
View return policy
Description
Paxillin is a focal adhesion protein and a substrate for several tyrosine kinases such as src, FAK, and p210BRC/ABL. The tyrosine phosphorylation of paxillin is affected by conditions that change cell-cell adhesion. Paxillin associates tightly with FAK and Crk through its SH2 domain. This interaction is independent of the extracellular matrix. Although paxillin was initially discovered in fibroblasts, its phosphorylation may also be important during neurite extension during differentiation.Specifications
| Paxillin | |
| Polyclonal | |
| Unconjugated | |
| PXN | |
| paxillin, PXN | |
| Rabbit | |
| Antigen Affinity Chromatography | |
| RUO | |
| 19303, 486299, 5829 | |
| -20°C | |
| Liquid |
| Immunofluorescence, Western Blot, Immunohistochemistry (Paraffin), Immunocytochemistry | |
| 0.33 mg/mL | |
| PBS with 50% glycerol and 0.02% sodium azide; pH 7.3 | |
| P49023, Q8VI36 | |
| PXN | |
| Paxillin Fusion Protein Ag17702 | |
| 20 μL | |
| Primary | |
| Canine, Mouse, Human | |
| Antibody | |
| IgG |
Product Content Correction
Your input is important to us. Please complete this form to provide feedback related to the content on this product.
Product Title
Spot an opportunity for improvement?Share a Content Correction